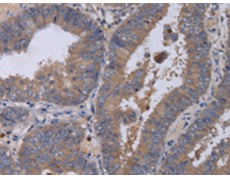
一抗

中文名稱: 兔抗MKKS多克隆抗體
英文名稱: Anti-MKKS rabbit polyclonal antibody
別 名: KMS; MKS; BBS6; HMCS
相關(guān)類別: 一抗
儲(chǔ) 存: 冷凍(-20℃)
宿 主: Rabbit
抗 原: MKKS
反應(yīng)種屬: Human
標(biāo) 記 物: Unconjugate
克隆類型: rabbit polyclonal
技術(shù)規(guī)格
|
Background: |
This gene encodes a protein which shares sequence similarity with other members of the type II chaperonin family. The encoded protein is a centrosome-shuttling protein and plays an important role in cytokinesis. This protein also interacts with other type II chaperonin members to form a complex known as the BBSome, which involves ciliary membrane biogenesis. This protein is encoded by a downstream open reading frame (dORF). Several upstream open reading frames (uORFs) have been identified, which repress the translation of the dORF, and two of which can encode small mitochondrial membrane proteins. |
|
Applications: |
ELISA, IHC |
|
Name of antibody: |
MKKS |
|
Immunogen: |
Fusion protein of human MKKS |
|
Full name: |
McKusick-Kaufman syndrome |
|
Synonyms: |
KMS; MKS; BBS6; HMCS |
|
SwissProt: |
Q9NPJ1 |
|
ELISA Recommended dilution: |
2000-5000 |
|
IHC positive control: |
Human colon cancer and human brain |
|
IHC Recommend dilution: |
50-200 |

 購(gòu)物車
購(gòu)物車 幫助
幫助
 021-54845833/15800441009
021-54845833/15800441009